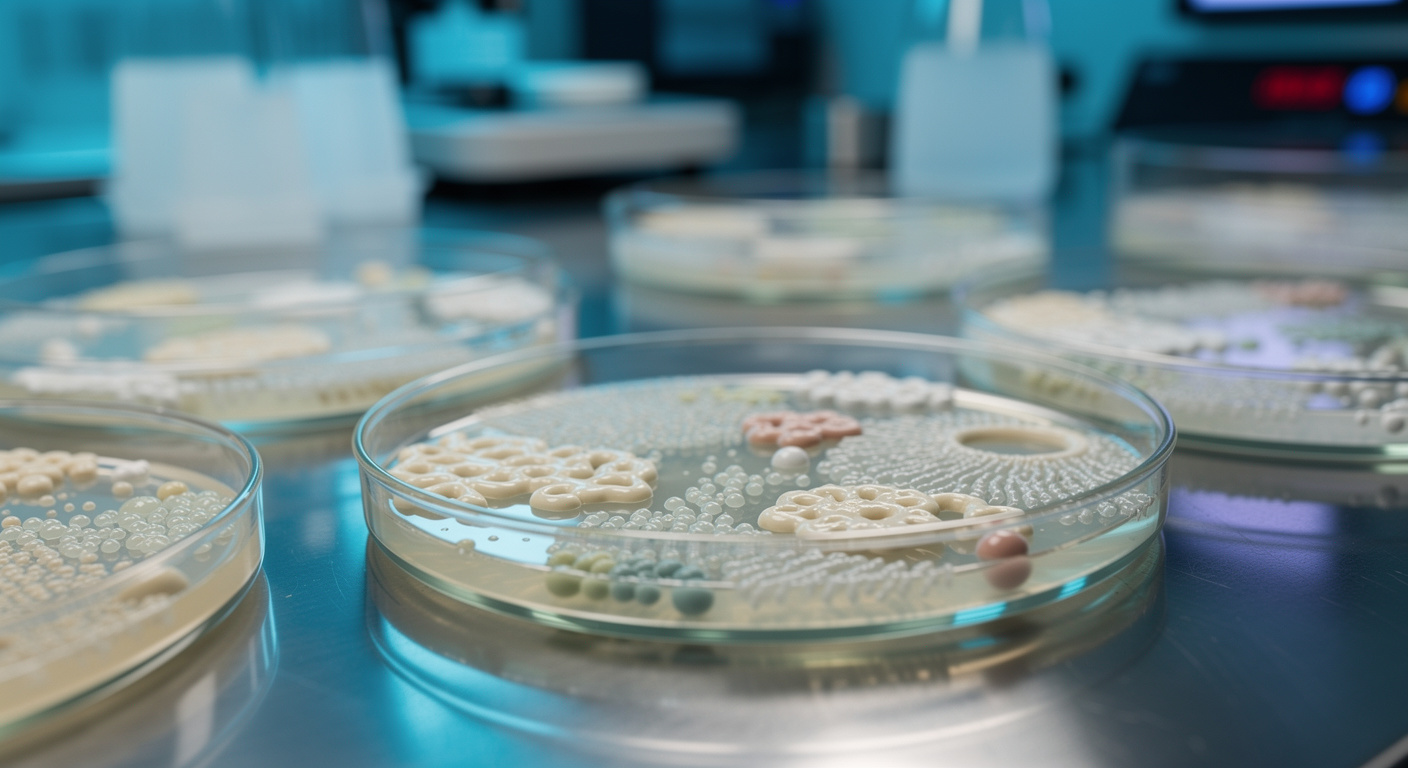

Alerte sanitaire : des lingettes nettoyantes courantes retirées de la vente après un décès
Auteur: Adam David
Une urgence sanitaire déclarée au Royaume-Uni

C’est une situation prise très au sérieux par les autorités britanniques. Une alerte sanitaire d’envergure a été déclenchée suite à la détection d’une série d’infections bactériennes graves au sein de la population. Les chiffres communiqués par les instances de santé font état de cinquante-neuf cas confirmés, dont l’issue a été fatale pour l’un des patients. Cette mobilisation fait suite à l’identification d’un vecteur de contamination inattendu : des lingettes nettoyantes utilisées quotidiennement.
L’enquête épidémiologique a permis d’isoler le coupable : la bactérie Burkholderia stabilis. Bien que cet agent pathogène soit considéré comme rare, sa présence dans des produits d’hygiène a suffi à provoquer une chaîne de contaminations inquiétante. Les agences sanitaires exhortent désormais les consommateurs à cesser immédiatement l’usage des lots incriminés pour éviter tout nouveau drame.
Cette crise met en lumière la vulnérabilité de certains produits de soin courants. Les investigations se poursuivent pour comprendre comment une telle contamination a pu se produire à l’échelle industrielle, tandis que le message principal reste la prévention immédiate auprès du grand public et des établissements de soins.
Comprendre la menace : qu’est-ce que la Burkholderia stabilis ?
Pour saisir la portée de cette alerte, il est nécessaire de se pencher sur la nature de l’agent infectieux. La Burkholderia stabilis est une bactérie que l’on retrouve naturellement dans l’environnement, notamment dans le sol et l’eau. Pour une personne en bonne santé, elle ne représente généralement aucun danger immédiat et cohabite avec notre écosystème sans provoquer de troubles notables.
Cependant, la situation change radicalement lorsque cette bactérie entre en contact avec des organismes fragilisés. Si elle parvient à pénétrer dans le corps humain via une plaie ouverte ou l’utilisation d’un dispositif médical, elle peut déclencher des infections sévères. Le tableau clinique peut s’assombrir rapidement, allant jusqu’à la septicémie, une réaction inflammatoire généralisée qui engage le pronostic vital.
Ce pathogène opportuniste cible donc prioritairement les individus dont les défenses immunitaires sont affaiblies. Sa détection dans des produits destinés à l’hygiène corporelle constitue une anomalie majeure, transformant un geste de soin anodin en risque médical sérieux.
Chronologie d’une contamination de longue durée

L’affaire ne date pas d’hier, comme le révèlent les investigations menées par la UK Health Security Agency (UKHSA) et l’agence du médicament britannique (MHRA). L’analyse rétrospective des dossiers médicaux a permis de remonter la piste de l’épidémie jusqu’en 2018, date des premiers cas recensés. Cette persistance dans le temps souligne la complexité de la traçabilité de ce type de contamination.
Le phénomène ne s’est pas arrêté et continue d’évoluer, les autorités mentionnant des détections d’infections s’étendant jusqu’en février 2026. Cette plage temporelle étendue démontre que des produits contaminés ont pu circuler et être stockés pendant de longues périodes dans les foyers ou les établissements de santé.
Les profils des victimes sont précis et confirment la nature opportuniste de la bactérie. La majorité des patients touchés présentaient des facteurs de comorbidité importants, tels qu’une immunodépression, une mucoviscidose, ou nécessitaient l’usage de dispositifs médicaux invasifs à domicile. Bien que le risque pour la population générale soit qualifié de faible, les conséquences pour ces patients fragiles ont été lourdes, justifiant l’hospitalisation de plusieurs personnes et causant un décès directement imputable à la bactérie.
Les produits incriminés : vérifiez vos placards

L’alerte vise spécifiquement des lingettes non stériles et sans alcool. Ces produits sont couramment employés pour la toilette, le nettoyage de plaies superficielles ou l’entretien de matériel médical domestique. Les autorités insistent : bien que retirées de la vente, ces lingettes peuvent encore dormir dans des armoires à pharmacie ou des trousses de secours.
Quatre références précises ont été formellement identifiées comme porteuses de la contamination :
- ValueAid Alcohol Free Cleansing Wipes
- Microsafe Moist Wipe Alcohol Free
- Steroplast Sterowipe Alcohol Free Cleansing Wipes
- Reliwipe Alcohol Free Cleansing Wipes
La consigne est stricte : si vous possédez l’un de ces paquets, il doit être jeté immédiatement, quel que soit son état. Même si l’emballage semble intact et n’a jamais été ouvert, le risque de contamination interne demeure présent. Ces produits ne doivent en aucun cas être utilisés, particulièrement sur une peau lésée ou une voie intraveineuse.
Rappel des règles d’or pour le soin des plaies

Cette crise sanitaire est l’occasion pour les professionnels de santé de rappeler les fondamentaux de l’hygiène médicale à domicile. La distinction entre un produit « propre » et un produit « stérile » est cruciale. Une lingette standard, même destinée au corps, n’est pas adaptée au traitement d’une effraction cutanée profonde ou à la manipulation de dispositifs invasifs comme les cathéters.
Pour nettoyer une blessure en toute sécurité, il est impératif de vérifier l’étiquetage : la mention « stérile » doit apparaître clairement. À défaut, les autorités recommandent de privilégier des méthodes plus simples et souvent plus sûres, comme le nettoyage à l’eau potable ou l’utilisation exclusive de matériel médical certifié stérile.
Les patients gérant des soins à domicile doivent redoubler de vigilance. L’utilisation de lingettes non stériles sur une voie veineuse ou une plaie ouverte constitue une porte d’entrée royale pour les bactéries. En cas de doute sur la nature d’un produit, l’abstention est la règle la plus prudente.
Que faire en cas d’exposition ?

Les interrogations sont légitimes pour quiconque a utilisé ces produits récemment. Les experts se veulent rassurants mais vigilants : si une lingette concernée a été utilisée, il faut cesser son emploi immédiatement et s’en débarrasser. Il convient ensuite d’observer attentivement la zone traitée.
Les signes qui doivent alerter sont classiques mais ne doivent pas être ignorés : apparition de rougeurs, sensation de douleur accrue, fièvre ou écoulement suspect au niveau de la plaie. Ces symptômes peuvent indiquer un début d’infection nécessitant une prise en charge médicale rapide.
Les populations à risque — nourrissons, personnes âgées, patients atteints de maladies chroniques ou porteurs de perfusions — sont invitées à consulter un professionnel de santé au moindre doute. La rapidité de la réaction est souvent déterminante pour éviter les complications graves décrites par l’agence de sécurité sanitaire.
Selon la source : passeportsante.net
Créé par des humains, assisté par IA.










